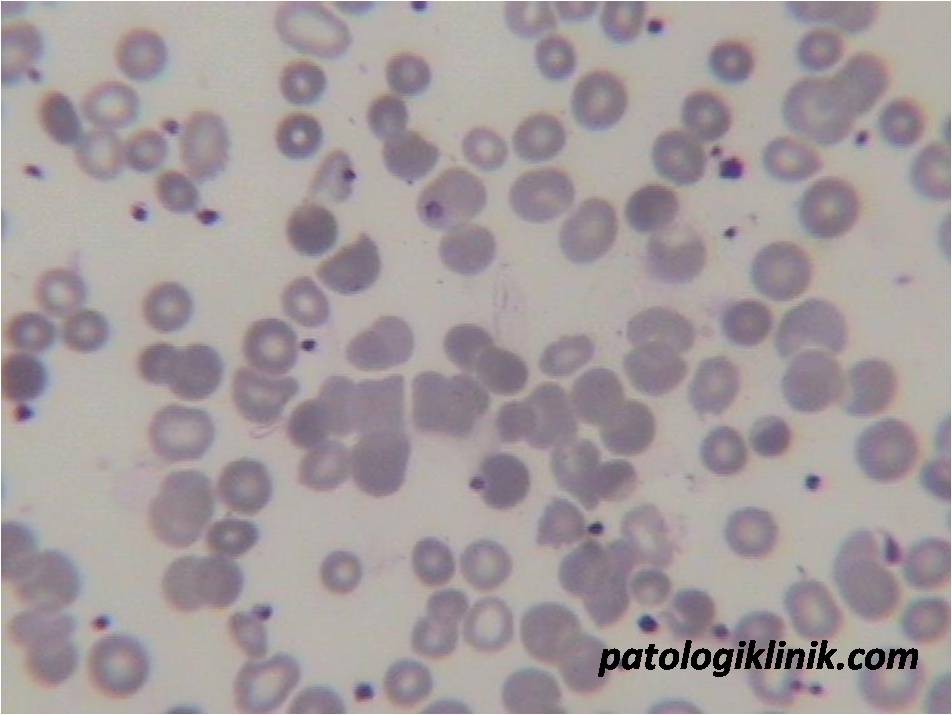
Gambaran Autoaglutinasi pada AIHA
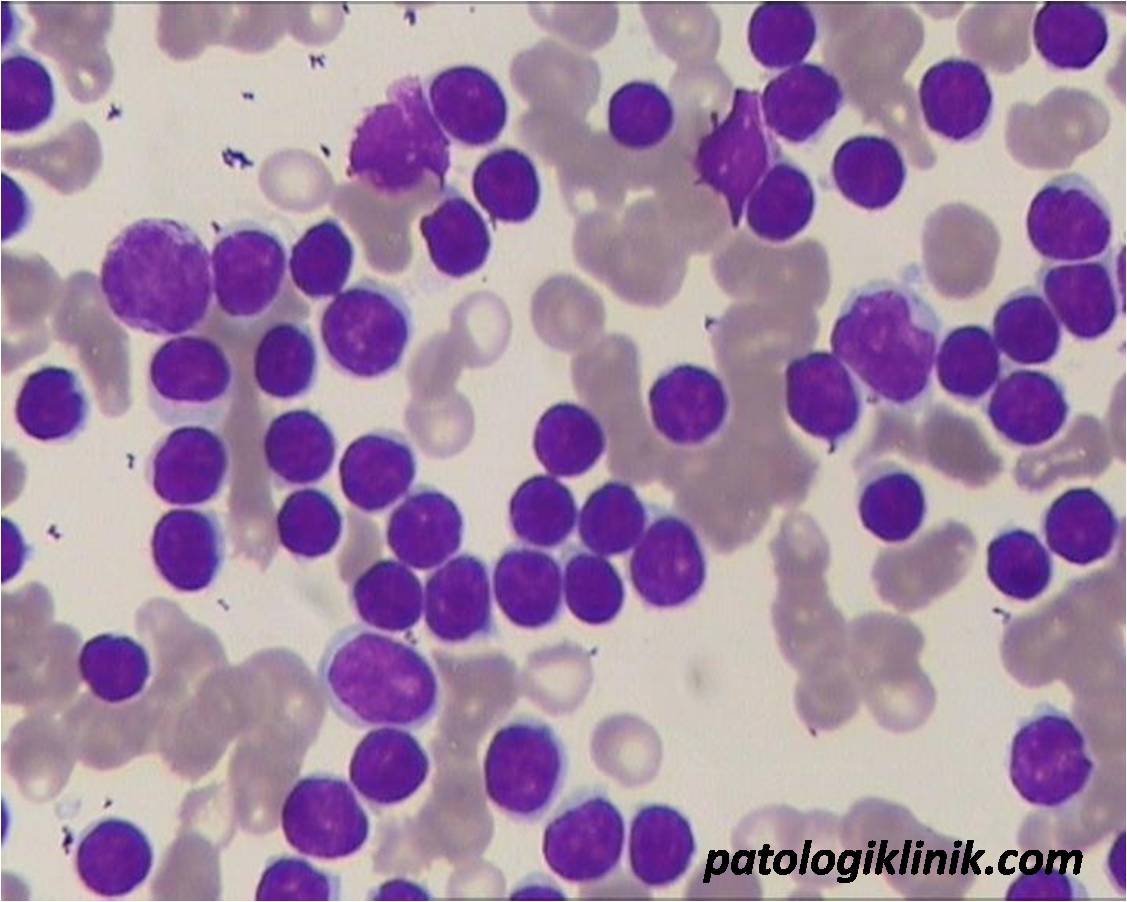
Chronic Lymphocytic Leukemia (CLL)

Megakariosit Staghorn pada Essential Thrombocytemia
Megakariosit pada essential thrombocytemia (ET) memiliki ciri: * ukuran besar (10-30x lebih besar dari eritrost) * inti berbentuk seperti tanduk rusa (staghorn) dengan multilobus 6-10 * sitoplasma luas (rasio inti:sitoplasma rendah) berwarna ungu kebiruan * tidak ada nukleoli